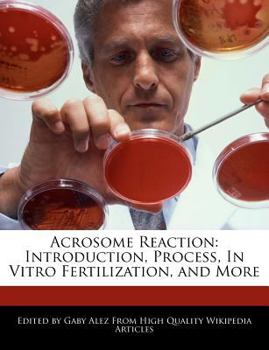
Paperback Acrosome Reaction: Introduction, Process, in Vitro Fertilization, and More Book

Acrosome Reaction: Introduction, Process, in Vitro Fertilization, and More
Please note that the content of this book primarily consists of articles available from Wikipedia or other free sources online.
This book is about the acrosome reaction, which is the reaction that occurs in the acrosome of the sperm as it approaches the egg. Read about the overview of the acrosome reaction, variations among species, cortical reaction, and everything in between.
Project Webster represents a new publishing paradigm, allowing disparate content sources to be curated into cohesive, relevant, and informative books. To date, this content has been curated from Wikipedia articles and images under Creative Commons licensing, although as Project Webster continues to increase in scope and dimension, more licensed and public domain content is being added. We believe books such as this represent a new and exciting lexicon in the sharing of human knowledge.
This book is about the acrosome reaction, which is the reaction that occurs in the acrosome of the sperm as it approaches the egg. Read about the overview of the acrosome reaction, variations among species, cortical reaction, and everything in between.
Project Webster represents a new publishing paradigm, allowing disparate content sources to be curated into cohesive, relevant, and informative books. To date, this content has been curated from Wikipedia articles and images under Creative Commons licensing, although as Project Webster continues to increase in scope and dimension, more licensed and public domain content is being added. We believe books such as this represent a new and exciting lexicon in the sharing of human knowledge.
Format:Paperback
Language:English
ISBN:127620406X
ISBN13:9781276204064
Release Date:January 1
Publisher:Webster's Digital Services
Length:172 Pages
Weight:0.70 lbs.
Dimensions:0.4" x 7.4" x 9.7"
Customer Reviews
0 rating